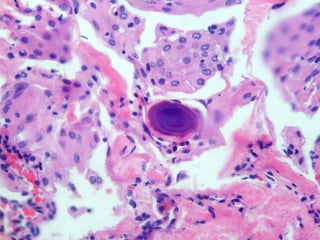
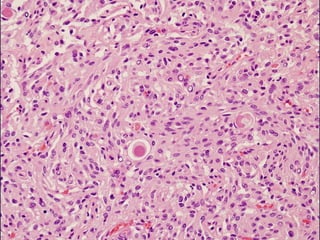
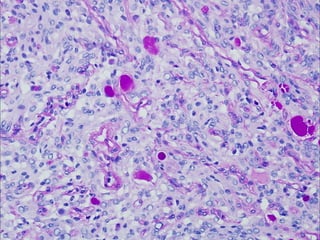
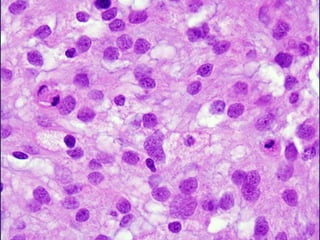

The study explores the integration of histopathology and complex genomic data to enhance the identification of distinct subgroups of meningiomas, influencing clinical care. Notably, new molecular signatures were discovered, alongside a reclassification of certain neoplasms based on genomic findings. This approach indicates that histological and genetic assessments collectively improve diagnosis and management for meningioma patients.